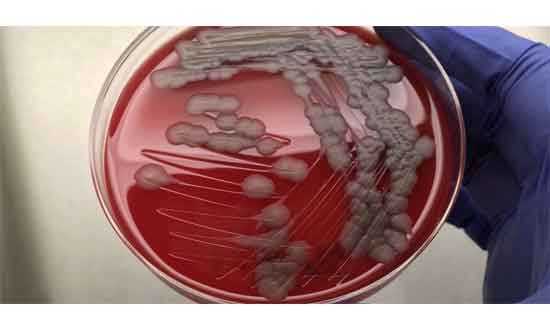

অ্যানথ্রাক্স কী, কীভাবে ছড়ায়
ছবি: ইন্টারনেট থেকে সংগৃহীত
অ্যানথ্রাক্স একটি ব্যাকটেরিয়াজনিত জুনোটিক রোগ। যা প্রাণী থেকে মানুষের শরীরে ছড়াতে পারে। এর জীবানু মাটিতে বহু বছর ধরে বাঁচতে পারে এবং সংক্রমণ ঘটনাতে সক্ষম।
বাংলাদেশের উত্তরাঞ্চলে সম্প্রতি অ্যানথ্রাক্স রোগের প্রাদুর্ভাব দেখা দিয়েছে। রংপুর ও গাইবান্ধা জেলার অ্যানথ্রাক্স সংক্রমণ শনাক্ত হয়েছে।
ঘাস ও পানি খাওয়ার সময় মাটিতে থাকা ব্যাকটেরিয়া থেকে গবাদি পশু আক্রান্ত হচ্ছে
গবাদি পশু জবাইয়ের আগে ডাক্তারি পরীক্ষা নিয়ম থাকলেও কেউ মানছে না: অধিদপ্তর
রংপুরে পশু জবাইয়ের স্বাস্থ্য পরীক্ষার জন্য ৩৬টি মেডিকেল
টিম গঠন
এর আগে ২০০৯ ও ২০১০ সালের দিকে একবার সিরাজগঞ্জ ও পাবনা এলাকায় গবাদী পশু আক্রান্ত হয়েছে। তা মহামারির পর্যায়ে চলে গিয়েছিলো। পরবর্তীতে ওই সব এলাকা নিয়ন্ত্রণে এসেছে।
ময়মনসিংহ বাংলাদেশ কৃষি বিশ্ববিদ্যালয়ের মাইক্রোবায়োলজি বিভাগের শিক্ষক আরিফুল ইসলাম জানিয়েছেন, বর্ষার শেষে ও শুস্ক মৌসুমে (আগস্ট-অক্টোবর) এই রোগ বেশী দেখা দেয়। কারন এ সময় মাটিতে লুকিয়ে থাকা ব্যবটেরিয়া ঘাস ও পানির মাধ্যমে গরুসহ অন্যান্য প্রাণীর শরীরে প্রবেশ করে। নদী বিধৌত চরাঞ্চল ও বন্যা প্রবন এলাকায় এর ঝুঁকি বেশী বেশী।
গবাদী পশু আক্রান্ত হলে হঠাৎ জ্বর ও খাবারে অরুচি, শ্বাসকষ্ট, অস্থিরতা, হঠাৎ মৃতু্যৃ, প্রায়ই পূর্বলক্ষণ ছাড়া মৃত প্রাণীর নাক, মুখ বা পায়ু দিয়ে গাঢ় কালচে রঙ্গের রক্ত বের হয়, যা জমাট বাঁধে না।
একটি গরু আক্রান্ত হলে পুরো খামারে যত গরু আছে সব গরু আক্রান্ত হবে। এরপর তা পুরো এলাকার সব গরু একে এক আক্রান্ত হতে থাকবে। এতে সংক্রমণ ছড়িয়ে পড়ে। আগেই ভ্যাকসিন বা টিকা দিলে আক্রান্তের সংখ্যা কমবে।
মানুষ যে ভাবে
সংক্রমিত হয়
অসুস্থ বা মৃত প্রাণী জবাই করার সময়। সংক্রমিত গরু বা অন্যান্য মাংস কাটার সময়,সংক্রমিত মাংস খাওয়ার ফলেও আক্রান্ত হতে পারে।
মানুষের মধ্যে অ্যানথ্রাক্সের ধরন ও লক্ষণ হলো, ত্বকীয়, ফুসকুড়ি বা ঘা, আন্ত্রিক, পেটব্যাথা, বমি, রক্ত মিশ্রিত ডায়রিয়া, শ্বাসনালী, কাশি, জ্বর ও শ্বাসকষ্ট।
উচ্চ ঝুকিপূর্ণ জনগোষ্ঠি
কসাই ও জবাই খানার কর্মী, মাংস কাটা ও বিক্রির কাজে যুক্ত নারী ও পুরুষ শ্রমিক,পশু পালক ও খামারকর্মী,সংক্রমিত এলাকায় বসবাসকারি সাধারণ জনগণ।
এই সংক্রমণ প্রতিরোধে গবাদি পশুর টিকা নিয়মিত দেয়া,অসুস্থ প্রাণী জবাই ও মাংস খাওয়া নিষিদ্ধ, মৃত প্রাণী নিরাপদে চুন মিশিয়ে পুঁতে ফেলা। কাজের সময় গ্লাভস, মাস্ক ও আ্যাপ্রন ব্যবহার। ক্ষতযুক্ত হাতে সংক্রমিত প্রাণী বা মাংস না ধরা। ত্বেক ক্ষত বা জ্বর দেখা দিলে দ্রুত চিকিৎসকের পরামর্শ নেয়া।
কী বলছেন বিশেষজ্ঞরা
অ্যানথ্রাক্স প্রাণী ও মানুষের জন্য সমান বিপজ্জনক, তবে এটি প্রতিরোধযোগ্য। নিয়মিত টিকা, অসুস্থ্য প্রাণী জবাই বন্ধ এবং স্বাস্থ্যবিধি মেনে চললেই সংক্রমণ রোধ করতে পারে। অ্যানথ্রাক্স প্রতিরোধে টিকা, অসুস্থ প্রাণী জবাই বন্ধ করার পরামর্শ দিয়েছেন।
প্রাণী সম্পদ অধিদপ্তরের উপ-পরিচালক (স্বাস্থ্য) শেখ শাহিনুর ইসলাম জানিয়েছেন, গরুসহ অন্যান্য গবাদী পশু জবাই করার আগে ভেটেনারী ডাক্তার দিয়ে পরীক্ষা করার নিয়ম আছে। তা কেউ মানছে না। অনেকেই গোপনে আক্রান্ত গরু জবাই করে । এতে রোগ ছড়ায়। মানুষও আক্রান্ত হয়। নিয়ম না মেনে গরু জবাই করা হচ্ছে বলে অভিযোগ তার।
অসুস্থ গরু জবাই করে না খেলেও জবাই প্রক্রিয়ার সঙ্গে জড়িত সবাই আক্রান্ত হবে।
যা বলছে মন্ত্রণালয়
মৎস্য ও প্রাণিসম্পদ মন্ত্রণালয়ের সিনিয়র তথ্য অফিসার মামুন হাসান রোববার,(০৫ অক্টোবর ২০২৫) জানিয়েছেন, অ্যানথ্রাক্্র বা তড়কা প্রতিরোধে প্রাণিসম্পদ অধিদপ্তর জরুরি ও সমন্বিত কার্যক্রম গ্রহণ করছে।
প্রাণিসম্পদ অধিদপ্তর স্থানীয় প্রশাসনের সমন্বয়ে টিকাদান, স্বাস্থ্য পরীক্ষা, উঠান বৈঠক, পথসভা, লিফলেট বিতরণ ও মাইকিং কার্যক্রম অব্যাহত আছে।
মন্ত্রণালয় থেকে জানিয়েছে, অসুস্থ্য পশু জবাই না করে ,মৃত পশুকে খোলা স্থানে বা পানিতে না ফেলে বরং গভীরে মাটিচাপা দিতে হবে। পশু অসুস্থ হলে দ্রুত নিকটস্থ ভেটেরিনারি হাসপাতাল বা প্রাণিসম্পদ দপ্তরে যোগযোগ করার পরামর্শ দেয়া হয়েছে।
রংপুর ও গাইবান্ধা জেলাকে অ্যানথ্রাক্স বেশি আক্রান্ত এলাকা হিসাবে চিহ্নিত করে টিকাদান কর্মসূচি বাস্তবায়ন করা হচ্ছে। অতিসত্তর প্রাণিসম্পদ গবেষনা প্রতিষ্ঠান রংপুর বিভাগে প্রায় ৩০ লাখ টিকা করবরাহ করবে। যার মধ্যে রংপুর ও গাইবান্ধা জেলাতে ২০ লাখ টিকা পাঠানো হবে।
সরজমিনে খোঁজ নিয়ে ব্যবস্থা নিতে রংপুর ও গাইবান্ধায় পৃথক ইনভেস্টিগেশন টিম পাঠানো হয়েছে।
রংপুর জেলার ৩৬টি কসাইখানায় গবাদী পশু জবাইর স্বাস্থ্য পরীক্ষার জন্য ৩৬টি মেডিকেল টিম গঠন করা হয়েছে।
গাইবান্ধার সুন্দরগঞ্জে আক্রান্ত পশুর নমুনা পরীক্ষা করা শুরু হয়েছে। ১১টি মাংসের নমুনার মধ্যে ১০টির পজেটিভ পাওয়া গেছে। প্রাণী সম্পদ অধিদপ্তরের উচ্চ পর্যায়ের অনুসন্ধানী টিম গঠন করছে। তারা আক্রান্ত এলাকা পরিদর্শন করে তাদের মতামত দিবেন।
স্থানীয়দের অভিযোগ প্রাণি সম্পদ অধিদপ্তরের জেলা ও উপজেলা পর্যায়ে যোগাযোগ করলেও তারা গ্রামগঞ্জে গিয়ে খোজ নেয়না। টিকাও দেয়না। বাধ্য হয়ে অনেকেই গ্রাম্য হাতুড়ে কবিরাজের ওষুধ খাইয়ে এখনো পশু বাঁচানোর চেষ্টা করছেন।
দেশে এখন ৭ লাখেরও বেশী খামারী আছে।
তাদের কাছে এখন ২ কোটি ৪৮ লাখ গবাদী পশু রয়েছে। বছরে প্রায় ৭০ লাখ ভ্যাকসিন তৈরী করা হয়। অতিরিক্ত ভ্যাকসিন তৈরীর উদ্যোগ নেয়া হয়েছে।
-

নির্বাচনের আগেই তিস্তা মহাপরিকল্পনার কাজ শুরুর দাবিতে ডিসি অফিস ঘেরাও
-

খাগড়াছড়ি: ৮ দিন পর ১৪৪ ধারা প্রত্যাহার
-

নীলফামারীতে টর্নেডো: ৫ শতাধিক ঘর বাড়ি বিধ্বস্ত
-

কাঁচামরিচের বাড়তি দাম থেকে কেজিতে ১০০ টাকা কমেছে
-

ডেঙ্গু: একদিনে সর্বোচ্চ ৯ জনের মৃত্যু
-

নবীগঞ্জে ট্রাক-পিকআপ সংঘর্ষে নিহত ১
-

হাজীগঞ্জে খাল ভরাটে পৌরবাসীর ক্ষোভ
-

পাহাড়ের পর্যটন জোন ঘিরে চকরিয়া লামা সড়ক ডাকাতের অভয়ারণ্য
-

সিংগাইরে নিখোঁজর ২ দিন পর জেলের লাশ উদ্ধার
-

ডিমলার সীমান্তে ফেনসিডিল ও ইয়াবা উদ্ধার
-

দশমিনায় বিয়ের আগের রাতে বরের আত্মহত্যা
-

মোহনগঞ্জে বিশ্ব শিক্ষক দিবস পালিত
-
মহাসড়কে অবৈধ পার্কিংয়ের দায়ে ইলিয়টগঞ্জে পাঁচ বাস জব্দ
-

উখিয়ায় আগ্নেয়াস্ত্র ও ইয়াবাসহ ৪ কারবারি গ্রেপ্তার
-

গৌরনদীতে বাস চাপায় নিহত ১
-

গ্রিনহাউসের আদলে দেশীয় কৃষিতে পলিনেট হাউস
-

দুমকিতে বিশ্ব শিক্ষক দিবস পালিত
-

মঠবাড়িয়ায় অভিজ্ঞ টেকনিশিয়ান ছাড়াই চলছে ডায়াগনস্টিক
-

দেশের ভেতরে ও উজানে ভারি বৃষ্টি, লালমনিরহাটসহ চার জেলায় বন্যার আশঙ্কা
-

বিশ্ব শিক্ষক দিবসে ঠাকুরগাঁওয়ে শিক্ষার্থীদের উচ্চবৃত্তি প্রদান
-

নরসিংদীতে পুলিশের ওপর হামলার ঘটনায় সাতজন গ্রেপ্তার
-

জয়পুরহাট ইয়াবাসহ স্বামী-স্ত্রী আটক
-
বেগমগঞ্জে দুটি হত্যাকান্ডর ঘটনায় জনমনে আতংক
-

হাসপাতালের সামনের রাস্তা খানাখন্দে ভরা, দুর্ভোগে রোগী ও স্বজনরা
-

শরণখোলায় হাজত থেকে পালানো আসামী আটক
-

৯৫ বছরেও সংসারের কাজে নিরলস গারো নারী বানদ্রি নকরেক
-

গঙ্গাচড়ায় আকস্মিক ঘূর্ণিঝড়ে ৮ শতাধিক ঘরবাড়ি বিধ্বস্ত
-

ক্ষতিপূরণ না পেয়ে ইকোপার্ক নির্মাণ কাজ বন্ধ করে দেয় এলাকাবাসী